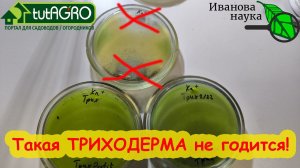
ЭТА ТРИХОДЕРМА ПОГУБИТ ВАШИ РАСТЕНИЯ! Какую триходерму нельзя использовать в саду и огороде.

2:15
2:15
2023-08-26 19:28

 2:36
2:36

 2:36
2:36
2023-08-30 18:49

 7:04
7:04

 7:04
7:04
2026-02-23 12:01

 5:31
5:31

 5:31
5:31
2025-02-10 16:14
![Семена прорастают в 3 раза быстрее чем в тряпочке! Как прорастить семена помидор и перца в губках?]() 2:01
2:01
 2:01
2:01
2021-01-12 14:21

 4:14
4:14
4:14
4:14
2023-12-18 13:00

 8:21
8:21

 8:21
8:21
2023-08-27 21:13

 3:09
3:09

 3:09
3:09
2025-02-14 14:51

 26:06
26:06

 26:06
26:06
2025-07-04 13:00

 51:10
51:10

 51:10
51:10
2025-09-19 18:45

 3:36
3:36

 3:36
3:36
2023-12-06 23:20

 20:03
20:03

 20:03
20:03
2023-03-03 07:00

 14:44
14:44

 14:44
14:44
2026-01-22 21:10

 44:06
44:06

 44:06
44:06
2025-08-22 18:02

 3:43
3:43

 3:43
3:43
2025-02-17 18:01

 4:43:57
4:43:57

 4:43:57
4:43:57
2025-04-18 11:30

 5:53
5:53
![KOBZOV - Королева Снежная (Премьера клипа 2026)]() 3:14
3:14
![Эстрада шоу гурухи - Шахзодам (Премьера клипа 2026)]() 2:54
2:54
![Sevil Sevinc – Sənsizlik (Official Video 2026)]() 3:30
3:30
![DAASHA - Сердце на полку (Премьера клипа 2026)]() 2:13
2:13
![Вика Ветер - Ты не забывай меня (Премьера клипа 2026)]() 3:57
3:57
![DJ Serzh - Аморе мио (Премьера клипа 2026)]() 3:36
3:36
![Румина Ашурова - Сынок (Премьера клипа 2026)]() 2:44
2:44
![Рейсан Магомедкеримов - Опасная (Премьера клипа 2026)]() 3:41
3:41
![Альбина Царикаева - Душа (Премьера клипа 2026)]() 3:16
3:16
![Артур Халатов - Не моя (Премьера клипа 2026)]() 3:28
3:28
![Дана Лахова - Ночь, ночь (Премьера клипа 2026)]() 3:01
3:01
![Скандальная пара - Душе моей душа нужна (Премьера клипа 2026)]() 3:40
3:40
![SANJA LAZIC - SVILA I VANILA (Official Video 2026)]() 3:13
3:13
![Алишер Абдугофуров - Кизимиз (Премьера клипа 2026)]() 4:20
4:20
![Тон Дуэт - Время (Премьера клипа 2026)]() 3:36
3:36
![Женя Белоусова - Ты мой (Премьера клипа 2026)]() 3:33
3:33
![Наталья Влади - Пожелаю тебе (Премьера клипа 2026)]() 2:29
2:29
![Гузэлем - Рамазан (Премьера клипа 2026)]() 2:45
2:45
![Сарвар Азим - Ашким (Премьера клипа 2026)]() 3:08
3:08
![Manzura - Yuragim ko'nikmaydi (Official Video 2026)]() 4:02
4:02
![Побег из плена | Prisoner of War (2025)]() 1:52:58
1:52:58
![Игры Биста. 2 сезон, 6 серия | Beast Games 2 season]() 1:01:28
1:01:28
![Пункт назначения: Узы крови | Final Destination: Bloodlines (2025)]() 1:49:52
1:49:52
![Казнить нельзя помиловать | Mercy (2026)]() 1:43:47
1:43:47
![Обитель зла 2: Апокалипсис | Resident Evil: Apocalypse (2004)]() 1:37:50
1:37:50
![Дом у дороги | Road House (2024)]() 2:03:29
2:03:29
![Кровь на границе | Frontier Crucible (2025)]() 2:04:36
2:04:36
![Орудия | Weapons (2025)]() 2:08:34
2:08:34
![Иерархия | Hierarchy (2025)]() 1:39:35
1:39:35
![Охотник и охотница | Hunting Grounds (2025)]() 1:29:24
1:29:24
![Опасный дуэт | The Wrecking Crew (2026)]() 2:04:21
2:04:21
![Безымянная романтическая история о вторжении в дом | Untitled Home Invasion Romance (2025)]() 1:25:48
1:25:48
![Лило и Стич | Lilo & Stitch (2025)]() 1:49:28
1:49:28
![Лакомый кусок | The Rip (2025)]() 1:52:50
1:52:50
![Опасные связи | Bone Lake (2025)]() 1:30:07
1:30:07
![Фуриоса: Хроники Безумного Макса | Furiosa: A Mad Max Saga (2024)]() 2:28:15
2:28:15
![Обитель зла 4: Жизнь после смерти | Resident Evil: Afterlife (2010)]() 1:37:36
1:37:36
![Без обид | No Hard Feelings (2023)]() 1:43:51
1:43:51
![Одинокие волки | Wolfs (2024)]() 1:47:12
1:47:12
![Давид | David (2025)]() 1:49:18
1:49:18
![Тодли Великолепный!]() 3:15
3:15
![Енотки]() 7:08
7:08
![Школьный автобус Гордон]() 12:34
12:34
![Команда Дино. Исследователи Сезон 2]() 13:26
13:26
![Космический рейнджер Роджер Сезон 1]() 11:32
11:32
![Корги по имени Моко. Волшебный мир снов]() 8:60
8:60
![Простоквашино. Финансовая грамотность]() 3:27
3:27
![Команда Дино. Исследователи Сезон 1]() 13:10
13:10
![Поймай Тинипин! Королевство эмоций]() 12:24
12:24
![Монсики]() 6:30
6:30
![Последний книжный магазин]() 11:20
11:20
![Сборники «Оранжевая корова»]() 1:05:01
1:05:01
![Супер Дино]() 12:41
12:41
![МиниФорс]() 0:00
0:00
![Приключения Пети и Волка]() 11:00
11:00
![Панда и Антилопа]() 12:08
12:08
![Богатырята]() 11:00
11:00
![Лудлвилль]() 7:05
7:05
![Агент 203]() 21:08
21:08
![Кадеты Баданаму Сезон 1]() 11:50
11:50
![Снова в деле (2025) Netflix]() 1:54:23
1:54:23
![Аватар: Путь воды (2022)]() 3:12:39
3:12:39
![Сборник Синий Трактор]() 57:36
57:36
![ANNA ASTI - ЦАРИЦА ( Премьера клипа 2023 )]() 4:01
4:01
![Сборник Топ 20 Номеров за 2024 год - Уральские Пельмени]() 2:52:30
2:52:30
![Бандитский Петербург. Все серии подряд. 60fps]() 66:54:01
66:54:01
![КАМИН 4К 🔥 FIREPLACE 4K | Звуки камина и Треск огня]() 2:00:00
2:00:00
![СваТы 1 сезон(все серии)]() 2:17:36
2:17:36
![Хищник: Планета смерти | Predator: Badlands (2025)]() 1:47:25
1:47:25
![Ми–Ми–Мишки 💫 Звездная история 🙃 Все серии ✨ Мультики для детей]() 2:10:31
2:10:31
![Лунтик | Танцы 💃💃💃 Сборник мультиков для детей]() 46:30
46:30
![Аватар 3: Пламя и пепел фильм, 2025]() 3:09:06
3:09:06
![Маша и Медведь. Серия 1. Первая встреча]() 6:36
6:36
![Свои. Баллада о войне [2025, драма, военный]]() 1:29:27
1:29:27
![MAUR - Полетела (Премьера клипа 2025)]() 2:53
2:53
![Три Кота | Сборник замечательных серий | Мультфильмы для детей😃]() 1:03:03
1:03:03
![Максим ФАДЕЕВ feat. Григорий ЛЕПС - Орлы или вороны ft.и]() 4:38
4:38
![50 клипов шансона]() 3:12:53
3:12:53
![Сборник На Кухне | Уральские Пельмени]() 1:30:27
1:30:27
![28 лет спустя: Часть II. Храм костей | 28 Years Later: The Bone Temple (2026)]() 1:49:24
1:49:24

 5:53
5:53Скачать Видео с Рутуба / RuTube
| 256x144 | ||
| 640x360 | ||
| 1280x720 | ||
| 1920x1080 |
 3:14
3:14
2026-02-19 13:13
 2:54
2:54
2026-02-14 12:51
 3:30
3:30
2026-02-18 09:47
 2:13
2:13
2026-02-20 09:55
 3:57
3:57
2026-02-20 09:52
 3:36
3:36
2026-02-20 09:44
 2:44
2:44
2026-02-16 15:37
 3:41
3:41
2026-02-20 09:40
 3:16
3:16
2026-02-17 09:15
 3:28
3:28
2026-02-16 17:48
 3:01
3:01
2026-02-17 09:46
 3:40
3:40
2026-02-19 12:26
 3:13
3:13
2026-02-19 12:11
 4:20
4:20
2026-02-25 09:40
 3:36
3:36
2026-02-18 12:03
 3:33
3:33
2026-02-20 09:27
 2:29
2:29
2026-02-20 09:20
 2:45
2:45
2026-02-19 13:22
 3:08
3:08
2026-02-14 12:48
 4:02
4:02
2026-02-18 10:00
0/0
 1:52:58
1:52:58
2026-01-26 14:34
 1:01:28
1:01:28
2026-02-04 10:24
 1:49:52
1:49:52
2026-01-23 18:44
 1:43:47
1:43:47
2026-02-23 10:58
 1:37:50
1:37:50
2026-02-25 19:41
 2:03:29
2:03:29
2026-01-23 18:43
 2:04:36
2:04:36
2026-01-26 14:34
 2:08:34
2:08:34
2026-01-23 18:44
 1:39:35
1:39:35
2026-02-06 18:40
 1:29:24
1:29:24
2026-02-06 18:40
 2:04:21
2:04:21
2026-02-02 00:43
 1:25:48
1:25:48
2026-02-26 14:41
 1:49:28
1:49:28
2026-01-23 18:44
 1:52:50
1:52:50
2026-02-04 10:11
 1:30:07
1:30:07
2026-02-06 18:40
 2:28:15
2:28:15
2026-01-23 18:43
 1:37:36
1:37:36
2026-02-25 19:41
 1:43:51
1:43:51
2026-01-23 18:44
 1:47:12
1:47:12
2026-01-23 18:43
 1:49:18
1:49:18
2026-01-29 11:25
0/0
 3:15
3:15
2025-06-10 13:56
 7:08
7:08
2025-12-30 21:34
 12:34
12:34
2024-12-02 14:42
2021-09-22 22:54
2021-09-22 21:49
 8:60
8:60
2025-12-09 11:58
 3:27
3:27
2024-12-07 11:00
2021-09-22 22:45
 12:24
12:24
2024-11-27 13:24
 6:30
6:30
2022-03-29 19:16
 11:20
11:20
2025-09-12 10:05
 1:05:01
1:05:01
2025-12-12 12:24
 12:41
12:41
2024-11-28 12:54
 0:00
0:00
2026-02-28 16:25
 11:00
11:00
2022-04-01 17:59
 12:08
12:08
2025-06-10 14:59
2026-01-12 13:08
 7:05
7:05
2025-12-30 20:49
 21:08
21:08
2025-01-09 16:39
2021-09-22 21:17
0/0
Скачать популярное видео
Популярное видео
 1:54:23
1:54:23
2025-01-18 20:05
2025-06-17 19:00
2024-11-13 13:06
 4:01
4:01
2023-10-12 11:54
2025-01-13 14:00
2023-05-15 17:30
2024-12-19 00:00
 2:17:36
2:17:36
2025-07-24 20:55
 1:47:25
1:47:25
2025-11-27 03:58
2024-01-17 17:34
2024-08-05 22:22
2025-12-26 16:56
2015-02-06 15:18
2025-04-11 14:51
 2:53
2:53
2025-04-24 09:53
 1:03:03
1:03:03
2026-02-02 23:42
 4:38
4:38
2017-12-19 08:20
2022-12-22 16:10
2025-04-04 18:26
 1:49:24
1:49:24
2026-02-19 14:08
0/0

